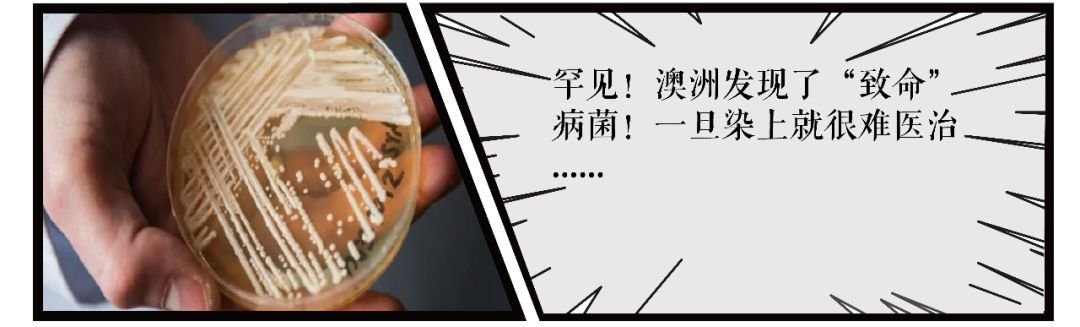

以为澳洲人真的很爱环保?以为外国人很有素质?一则禁塑令后揭示了土澳的土有多不堪!外国的月亮没有那么圆啊各位!
”
从国内出来留学生活的各位
可能你们都会感慨
哇,外国人的素质普遍比较好
哇,外国人都比较有礼貌
哇, 外国人真的挺绅士
之类的

然而外国的月亮真的比较圆?
歪果人的素质真比较好?
澳洲的一则禁塑令
可是暴露了不少土澳土人
让人目瞪口呆的恶习…
禁塑令引起各种偷超市篮,偷手推车回家恶习!



据《每日邮报》报道
自从澳洲所有超市在7月后推行禁塑令
尽管其背后的环保原意是好的
但是除了环保团体表示欢迎外
还是有不少消费者认为
购物的便捷性降低,表示不满

没错
禁塑令的出台
有环保概念的当然一篇叫好
但很可能抗拒、不习惯、不满的
也是大有人在的

没有塑料袋?我就偷手推车和超市篮!



据《每日邮报》报道
那些对禁塑令不满或不习惯的人
出现了各种令人咋舌的骚操作
例如上图的那人
去购物直接就把购物篮顺回家!

仿佛他们就习惯了
购物必须有塑料袋
像是天经地义一般
你不给我免费塑料袋就是欠我
那我拿购物篮回家很正常吧?

而以上的这些人
甚至还不知羞耻
直接把自己这些强盗般的动作
放上脸书等社交网络
来显示自己的逼格
结果这一行为仿佛陈胜起义一般
竟然引来一堆追随者分享强盗经验

甚至有大叔直接把超市手推车
给扛上车后备箱运回家!
没有免费塑料袋?
没关系!不是还有免费的手推车么!
免费的意思就是
都是我的!

记者后来发现几乎
悉尼的麦考瑞和Miranda区
都变成了抛弃手推车的重灾区

一条路上短短的十米不到
至少就堆了十部以上的手推车
可见有多少人直接把推车拉回家
而问题就来了
超市其实都明令禁止
手推车是不准离开商场范围外的!

那么那些擅自把
超市篮,手推车直接拉回家的人
其实就本着一个强盗逻辑:
超市不给我“应得”的免费袋子
那我就可以拿装东西的容器
重点是:免费随便拿!

然而要知道
以前提供免费塑料袋的时候
你能拿回家那算是你私人的
但超市篮,手推车,都是公用的!
性质本身就不一样

外国的月亮没比较圆,外国人的素质没比较好…

澳洲作为一个多民族国家
几乎融汇了全球各地的民族
尽管是典型的西方社会
只有亲身体会过的人才会知道
这里的月亮并没有比较圆

著名的澳青们
酗酒打架都是常规操作
留学生走路都习惯绕开他们
见到他们仿佛见到鬼见愁
心都碎了

而早前在澳洲投入的共享单车
别看初期排的整整齐齐

到了后面还是给你整的明明白白
还有人po上网炫耀
自己捣乱的战绩

又比如今天爆出的
禁塑令之后的各种“强盗逻辑”
直接从超市顺东西当袋子
足够证明外国人素质并没想象中完美

以上
不管我们身在何处
都要谨记道德不能丢
这种群体性的道德崩坏狂欢
就像是“路西法效应”
一旦个人把持不住就容易随团堕落
有些事,黑白是分明的

来源:DM
编辑:凛桑


本文源自微信公众号:悉尼宝贝
本文来源于网络,不代表“最澳洲”观点。如您认为该资讯侵犯了您的权益,请通过本站侵权投诉页面进行申诉。:最澳洲 » 澳禁塑令众生相:直接顺购物篮回家!超市手推车走你!谁说外国人素质比较好?